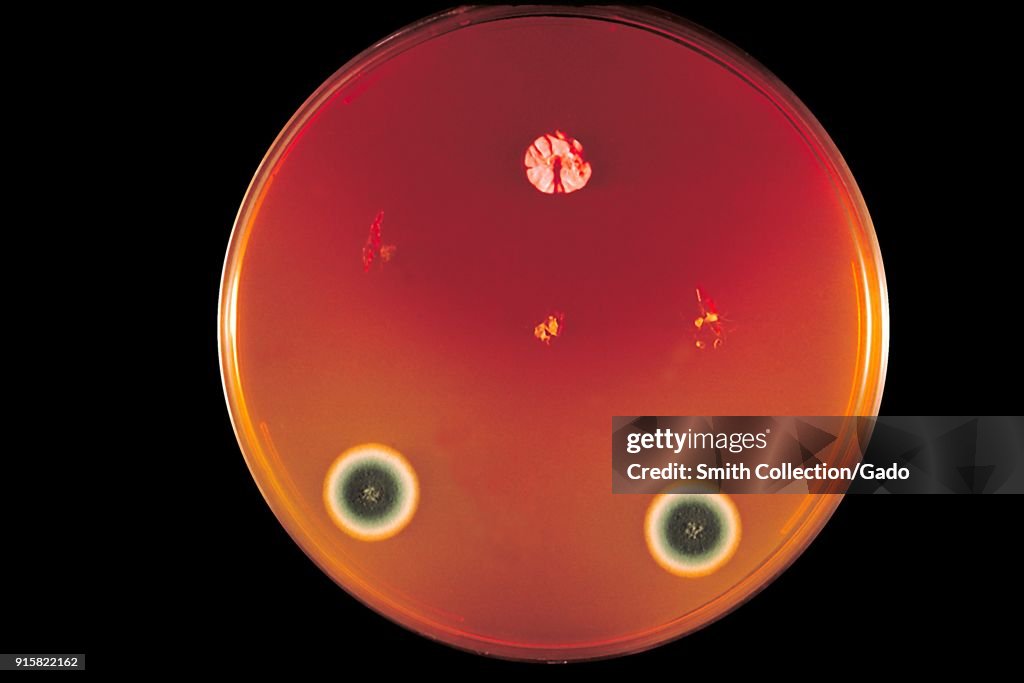
Trichophyton Concentricum

Trichophyton Concentricum
Plate culture growing the fungus Trichophyton concentricum, using a DTM (Dermatophyte Test Medium), 1970. Image courtesy Centers for Disease Control (CDC). Image courtesy CDC. (Photo by Smith Collection/Gado/Getty Images)
COMPRAR LICENCIA
¿Cómo puedo usar esta imagen?
AR$ 208.500,00
ARS
Getty ImagesTrichophyton Concentricum, Fotografía de noticias
Trichophyton Concentricum Consigue fotografías de noticias de alta resolución y gran calidad en Getty ImagesProduct #:915822162
Trichophyton Concentricum Consigue fotografías de noticias de alta resolución y gran calidad en Getty ImagesProduct #:915822162AR$329.200AR$88.100
Getty Images
In stockTen en cuenta lo siguiente: las imágenes que representan eventos históricos pueden contener temas, o tener descripciones, que no reflejan la comprensión actual. Se proporcionan en un contexto histórico. Más información.
DETALLES
Restricciones:
Póngase en contacto con su oficina local para conocer todos los usos con fines comerciales o promocionales.
Crédito:
Editorial n.º:
915822162
Colección:
Archive Photos
Fecha de creación:
01 de enero de 1970
Fecha de subida:
Tipo de licencia:
Inf. de autorización:
No se cuenta con autorizaciones. Más información
Fuente:
Archive Photos
Nombre del objeto:
92257final.jpg
Tamaño máx. archivo:
5300 x 3533 px (44,87 x 29,91 cm) - 300 dpi - 2 MB